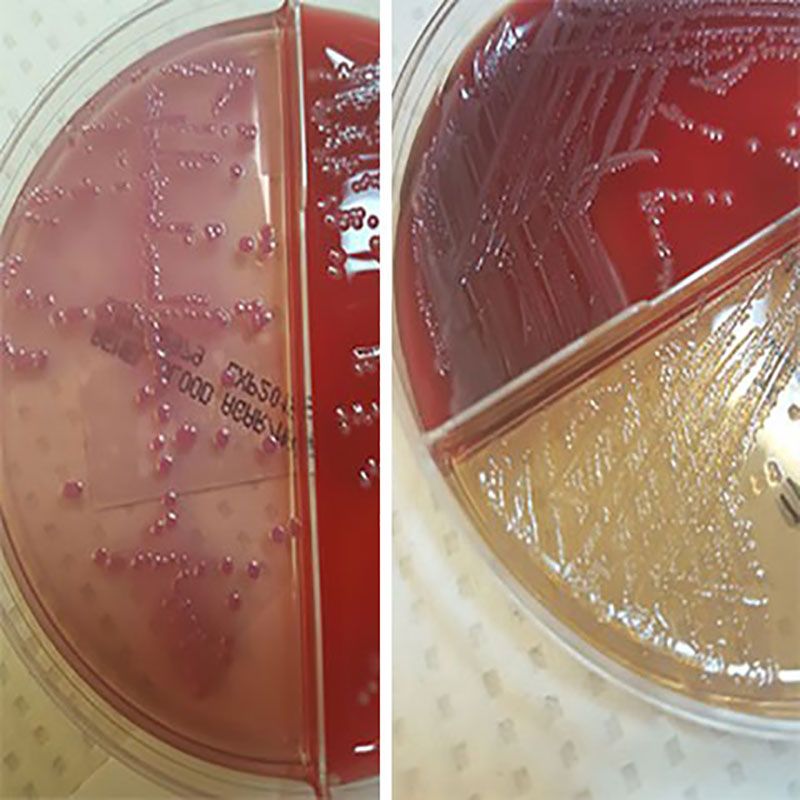

We want aploding the picture about Construction stages
It is as follows:

According to the images of the manufacturing and clinical testing stages, up to this stage, we had no impairment of vital signs, including breathing and heart rate, and with the feature of our refractive injections, we also prevented an increase in blood pressure, and this stage of the formulation was truly an amazing idea.